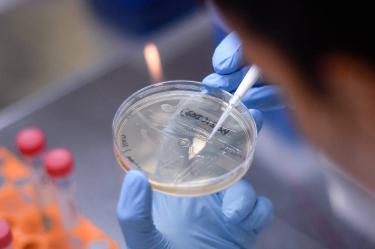
thumb

Plan de distribución de vacuna de covid sufre ciberataque
Investigadores de seguridad de IBM detectaron intentos de para tratar de recopilar información vital sobre la iniciativa de la OMS para distribuir la vacuna
BOSTON
Investigadores de seguridad de IBM dijeron que detectaron intentos de ciberespionaje con correos electrónicos de phishing dirigido para tratar de recopilar información vital sobre la iniciativa de la Organización Mundial de la Salud (OMS) para distribuir la vacuna contra el COVID-19 en países en desarrollo.
Vacuna anticovid se aplicará primero a médicos y adultos mayores
Los investigadores dijeron que no podían estar seguros de quién estaba detrás de la campaña, que comenzó en septiembre, o si ha tenido éxito. Pero la precisión del ataque y el cuidado para no dejar pistas tenían "el sello potencial de una acción estatal”, afirmaron en una publicación en un blog el jueves.
Los objetivos de la campaña, en países como Alemania, Italia, Corea del Sur y Taiwán, podrían estar relacionados con el desarrollo de la “cadena de frío" necesaria para garantizar que las vacunas contra el coronavirus reciben la refrigeración continuada que necesitan para ser efectivas para los casi 3.000 millones de personas que viven en lugares donde el almacenamiento con temperaturas controladas es insuficiente, señaló IBM.
Piensen en ello como una transfusión de sangre que suministrará las vacunas más vitales a nivel mundial", dijo Claire Zaboeva, una analista de IBM implicada en la detección.
Quienquiera que esté detrás de la operación podría estar motivado por el deseo de saber cómo se pueden enviar y almacenar mejor las vacunas — todo el proceso de refrigeración — para poder copiarlo, apuntó Nick Rossmann, jefe del equipo de amenazas de inteligencia global de IBM. O podrían querer poder socavar la legitimidad de una vacuna o lanzar un ataque desestabilizador, agregó.
México recibirá 250 mil vacunas este mes
En la trama, ejecutivos de grupos probablemente asociados con la iniciativa llamada Covax — creada por la Alianza para la Vacunación, la OMS y otras agencias de Naciones Unidas — recibieron emails falsos que parecían proceder de un ejecutivo de Haier Biomedical, una empresa china considerada el principal proveedor mundial de cadenas de frío, añadió.
Los correos electrónicos contenían archivos adjuntos maliciosos que pedían a los destinatarios que introdujesen sus credenciales, que podrían haber sido empleadas para recopilar información confidencial sobre socios vitales para la plataforma de reparto de vacunas.
Vacuna contra covid-19 será gratuita en México
Entre los objetivos estaban la Dirección General de Impuestos y Unión Aduanera de la Unión Europea y empresas que fabrican paneles solares para alimentar contenedores refrigerados portátiles para el fármaco. Entre los receptores había también compañías petroquímicas, probablemente porque producen hielo seco, que se emplea en la cadena de frío, añadió Zaboeva.
La agencia de la UE ha estado revisando nuevos regímenes de importación y exportación para las vacunas contra el coronavirus y podría ser una mina de oro para los hackers que buscan entrar a organizaciones asociadas, apuntó.
Covax ha tenido problemas para recaudar dinero suficiente para competir por contratos de vacunas con las naciones más ricas en una carrera para asegurarse las dosis lo más rápido posible. Pero la ONU y Gavi han invertido millones en equipos de mantenimiento de frío en África y Asia. La inversión, en la que ya se trabajaba antes de la pandemia, se aceleró para la posible distribución global de las vacunas contra el COVID-19.
asc
